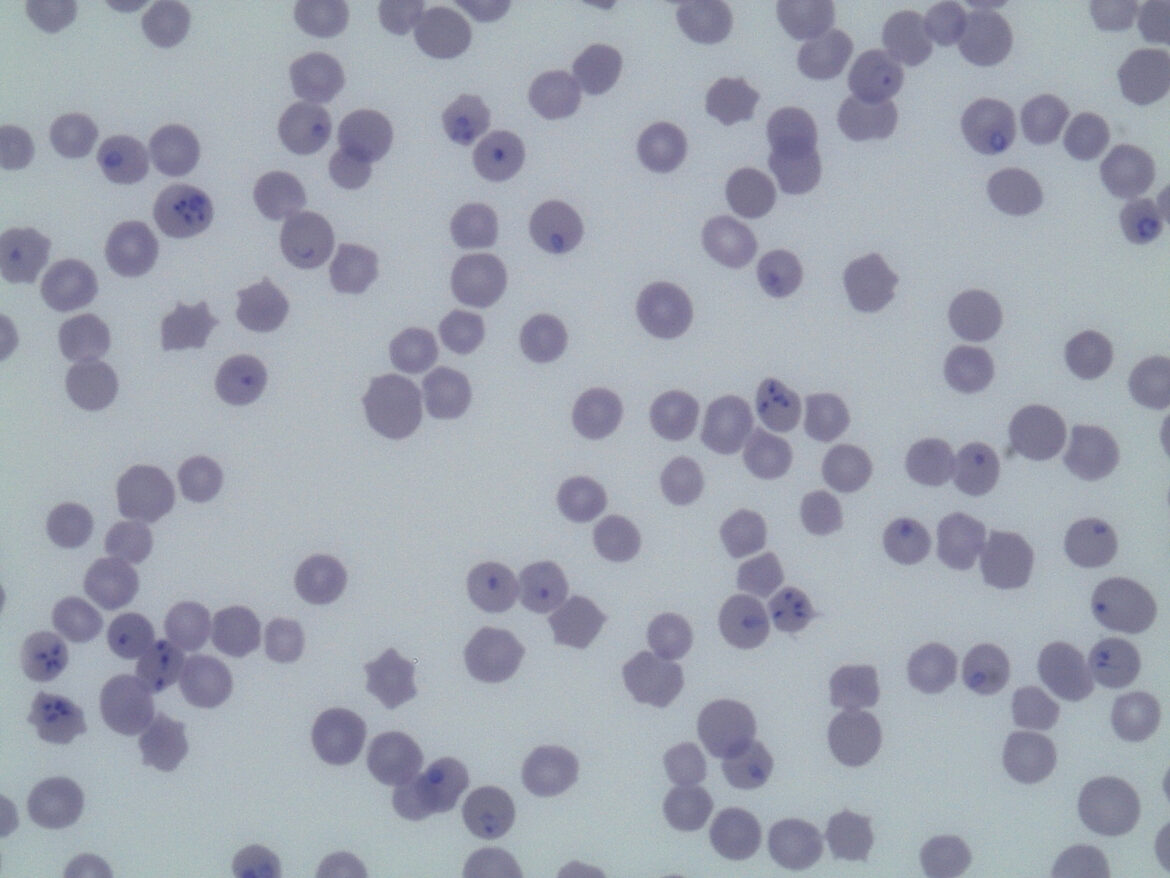

En las mejores manos
Atención clínica especializada, profesional y completa. Nuestras unidades móviles nos permiten ofrecer un servicio rápido y de gran alcance.
Cada caso clínico es único
Nuestro objetivo es el bienestar de tu cuadra. Nos implicamos en cada caso y ponemos a tu disposición todos los medios humanos y técnicos necesarios para obtener los mejores resultados.
SERVICIOS
Expertos en ozonoterapia
Pioneros en la aplicación de ozonoterapia dirigida a incrementar el rendimiento deportivo, control del dolor y curación de heridas de gravedad.
Quiénes somos
MC Veterinaria es el proyecto profesional de María de la Cuesta. Licenciada en veterinaria, máster en medicina interna equina y una de las primeras especialistas de nuestro país en ozonoterapia veterinaria. Su pasión por los caballos la mantiene vinculada al mundo universitario como profesora asociada e investigadora.
MC Veterinaria presta servicio veterinario ambulante en el ámbito de la Comunidad Valenciana y cuenta con un alto grado de fidelidad entre sus clientes. La dedicación, cercanía y exigencia profesional por parte de su equipo de veterinarios los ha convertido en clínica de referencia dentro y fuera de la Comunidad Valenciana.


María de la Cuesta Torrado. –
DVM, Maestría, Certificación. Esp. CEq
Fundadora en 2011 de MC Veterinaria, empresa dedicada a la clínica equina ambulante.
Responsable del Servicio de Medicina Interna Equina en MC Veterinaria.
María de la Cuesta, es además la responsable del Servicio de Medicina Interna Equina en el Hospital Clínico Veterinario de la Universidad Cardenal Herrera CEU en Valencia, España, cargo que ocupa desde 2021.
Se graduó en la misma universidad en 2006 y posteriormente se graduó un internado de dos años y un programa de posgrado en medicina interna equina durante tres años en la Universidad Alfonso X El Sabio en Madrid. María ha trabajado tanto en hospitales como en clínicas ambulantes y actualmente es profesora en la Facultad de Veterinaria de la Universidad Cardenal Herrera CEU en Valencia, además de su labor como jefa del Servicio de Medicina Interna Equina.
Su investigación se centra en el herpesvirus equino tipo 1 (EHV-1), especialmente en los aspectos clínicos y los factores que influyen en el desarrollo y la gravedad de la enfermedad. También participa activamente en otros proyectos e investigaciones en diversas áreas de la medicina interna equina. Su trabajo busca cerrar la brecha entre la práctica clínica y la investigación, mejorando los resultados para los pacientes equinos en todo el mundo. Cuenta con numerosas publicaciones científicas en revistas de reconocido prestigio por sus índices de calidad, así como artículos de divulgación.
María es además,
Codirectora Máster de Medicina y Cirugía Equina Universidad Tecnológica Tech
Autora Máster en Medicina y Cirugía Equina Universidad Tecnológica Tech
Autora Máster de Clínica Hospitalaria Equina Universidad Tecnológica Tech
Datos generales
- Licenciada en Veterinaria por la Universidad Cardenal Herrera CEU de Valencia, 2006
- Máster en Medicina Interna Equina por la Universidad Alfonso X el Sabio (2011).
- Realización de los cursos de doctorado y Diploma de Estudios Avanzados Universidad Complutense de Madrid (2010).
- Miembro del comité organizador del “ 12º Congreso del Colegio Europeo de Medicina Interna Equina 2019 (ECEIM )”
- Miembro de la junta directiva de la Sociedad Española de Ozonoterapia.
- Miembro de la comisión de clínicas del Colegio Oficial de Veterinarios de Valencia.
- Miembro de la Asociación Española de Veterinarios Especialistas en Équidos (AVEE).
Experiencia profesional
- Fundadora de MC Veterinaria en el año 2011, empresa dedicada a servicios veterinarios en clínica equina ambulante y que actualmente consta de 5 profesionales en plantilla, con ámbito de trabajo localizado en la Comunidad Valenciana.
- Responsable del Servicio de Medicina Interna Equina en MC Veterinaria
- Residencia de 3 años en Medicina Interna Equina (2008-2011, Universidad Alfonso X el Sabio de Madrid).
- Internado de 2 años en Clínica Equina 2006-2008, Universidad Alfonso X el Sabio de Madrid.
- Estancias de formación en varios centros hospitalarios nacionales e internacionales, así como centros de reproducción equina.
Docente experimentado
- Profesora Asociada del Departamento de Medicina y Cirugía Animal de la Universidad Cardenal Herrera CEU con docencia en áreas relacionadas con la medicina interna equina desde 2012.
- Responsable como empresa colaboradora con la Universidad Cardenal Herrera CEU, de la supervisión y tutela de alumnos que se encuentren realizando la asignatura de “ Prácticum ” en MC Veterinaria.
- Colaboración en la docencia de estudiantes del grado en veterinaria en la Universidad Alfonso X el Sabio de Madrid durante los años 2006-2011.
- Colaboración en la docencia y formación de veterinarios internos y residentes del hospital clínico veterinario en la Universidad Alfonso X el Sabio de Madrid durante los años 2006-2011.
Experiencia en investigación y participaciones en congresos:
- Publicaciones científicas en el área de la medicina interna equina.
- Participación en cursos y congresos nacionales e internaciones como autora de pósters o ponencias.
- Miembro del comité científico y coordinadora de cursos y congresos, en el área de la ozonoterapia, avalados por créditos de formación continuada otorgados por el Sistema Nacional de Salud.
- Asistente regular a jornadas, cursos y congresos nacionales e internacionales.

Irene Benito Bernáldez – DVM., Cert.Esp.C.Eq
Veterinaria clínica responsable del servicio de oftalmología y nutrición en MC Veterinaria desde 2014
Profesora asociada del Departamento de medicina y cirugía animal de la Universidad Cardenal Herrera CEU, desde 2019.
Coautora Máster de Medicina y Cirugía Equina Universidad Tecnológica Tech
Coautora Máster de Clínica Hospitalaria Equina Universidad tecnológica Tech
Certificado Español en Clínica Equina (CertEspCEq)
Veterinario oficial FEI (Fédération Equestre Internacionale)
Master título propio en medicina y cirugía equina Tech University
Experiencia profesional
- Veterinaria clínica de équidos en servicio ambulatorio en la empresa MC Veterinaria Equina desde el año 2014, en Valencia.
- Internado en Medicina y Cirugía Equina en el Hospital Clínico Veterinario de la UAB (Universidad Autónoma de Barcelona) durante el año 2013-2014.
Experiencia Docente
- Profesora asociada del Departamento de medicina y cirugía animal de la Universidad Cardenal Herrera CEU, desde 2019.
- Responsable de la organización y tutorización de los alumnos que realizan sus prácticas en la empresa de MC Veterinaria equina, tanto de carácter curricular como extracurricular, en convenio con la Universidad Cardenal Herrera CEU, y de otras universidades nacionales.
Formación
- Asistencia a los Congresos anuales de AVEE (Asociación de Veterinarios Especialistas en Équidos) como socia veterinaria desde el año 2017.
- Asistencia a cursos y jornadas de formación y actualización impartidas por universidades españolas.
- Actual miembro de la asociación Equine Sciencie Society para personal investigador, docencia y personal profesional de la industria ecuestre.

Sergio Gimeno – DVM., Cert.Esp.C.Eq
Veterinario clínico responsable del servicio de medicina deportiva en MC Veterinaria desde 2014
Profesor asociado del Departamento de medicina y cirugía animal de la Universidad Cardenal Herrera CEU, desde 2014.
Coautor Máster de Medicina y Cirugía Equina Universidad Tecnológica Tech
Certificado Español en Clínica Equina (CertEspCEq)
Veterinario oficial FEI(Fédération Equestre Internacionale)
Título de experto propio en patologías locomotoras del potro y el caballo adulto. Protocolos terapéuticos ampliados a la práctica ambulatoria Tech University
Director de instalaciones de radiodiagnóstico.
Experiencia profesional
- Veterinario clínico responsable del servicio de medicina deportiva en MC Veterinaria desde 2014
- Hospital veterinario de referencia “LA EQUINA” Veterinario interno 2012-2013
- Warren house veterinary centre UK Veterinario clínico Becado 2011
Experiencia docente
Universidad Cardenal Herrera CEU . Departamento de Medicina y Cirugía Animal Profesor asociado
Formación
- Licenciado en Veterinaria Valencia-España Universidad Cardenal Herrera CEU
- Estudios avanzados en investigación Valencia-España Universidad Cardenal Herrera CEU
- Miembro de la “international society of equine locomotor pathology” (ISELP)
2011-2014 Estancias formativas de veterinario visitante
- Clínica veterinaria equina fundación REAAE
- Hospital equino Aznalcollar
- Hospital veterinario de referencia “LA EQUINA”
- Hospital veterinario, Universidad de Budapest
Investigación
- 2019. Investigador veterinario en ensayos clínicos para el uso de fármacos en enfermedades locomotoras. (Ondax Scientific)
- 2017. Investigador veterinario en los ensayos clínicos para el uso de células madre. Equicord-Ymas
- 2018. Certificado para la función C, Curso de experimentación animal. Universidad Cardenal Herrera CEU 2018

Nuria Tortajada González – DVM
Veterinaria clínica generalista en MC Veterinaria desde 2021
Profesora asociada del Departamento de medicina y cirugía animal de la Universidad CEU Cardenal Herrera de Valencia, desde 2020.
Experiencia Profesional
- Veterinaria clínica de équidos en servicio ambulatorio en la empresa MC Veterinaria Equina desde febrero 2021, en Valencia y dirigida por María de la Cuesta.
- Veterinaria Clínica en el Hospital Clínico Veterinario CEU de Noviembre 2019 – Enero 2021.
- Internado en Medicina y Cirugía Equina en el Hospital Clínico Veterinario San Vicente del Raspeig durante el año 2019-2020.
- Becaria en Administración y Dirección del Hospital Clínico Veterinario CEU durante el año 2018-2019.
Experiencia Docente
- Profesora asociada del departamento medicina y cirugía animal de la Universidad CEU Cardenal Herrera.
- Experiencia en investigación.
- Trabajo final de grado experimental titulado “Eventos adversos en caballos hospitalizados en un hospital de referencia equina ” en Julio de 2019.
- Monitorización de la FC y Tª del caballo de picar durante su participación en el festejo taurino. Septiembre 2019. Proyecto ganador en el XIV Symposium del Toro de Lidia.
Formación Académica
- Máster de medicina y cirugía equina de la Universidad tecnológica TECH. Septiembre 2021.
- Asistencia a cursos y jornadas impartidas por la AVEE (Asociación de Veterinarios Especialistas en Équidos).
- Asistencia a cursos y jornadas de formación y actualización impartidas por universidades españolas

Jesús Bravo Muñoz – DVM
Veterinario clínico generalista equino.
Máster título propio en medicina y cirugía equina Tech University.
Experiencia profesional
- Hospital Equino de Aznalcóllar Sevilla, España. Veterinario Interno 2018-2019.
- Veterinario generalista equino en HVT Veterinarios en Murcia, España 2019.
- Veterinario equino ambulante en Jaén, España desde 2019.
- Veterinario clínico en el Hospital Clínico Veterinario CEU Cardenal Herrera en Valencia, España 2021-2023.
Formación profesional:
- Graduado en Veterinaria por la Universidad CEU Cardenal Herrera
- Realización de estancias prácticas en hospitales de referencia en España como: La Equina en Manilva, España y en el Instituto Español de Genética y Reproducción Animal Talavera de la Reina, España durante la carrera universitaria.
Formación Académica:
- Curso de cirugía artroscópica como el Intermediate Equine Arthorscopy Course impartido por cirujanos de renombre como Fabrice Rossignol, Ann Martens y Luis Rubio.
- Asistencia a congresos de enfoque nacional como el Salón Internacional del Caballo (SICAB).
- Asistencia a congresos, cursos y jornadas de formación relacionados con la actividad clínica equina por universidades españolas.
MC Veterinaria cuenta con tres unidades móviles disponibles 24 horas durante todo el año
Nuestro completo y moderno equipamiento nos permite realizar análisis clínicos, endoscopias de vías respiratorias altas, ecografías, electrocardiografías y pruebas radiológicas concertadas



Servicios

La medicina interna es la clave de la buena salud en el caballo. Esta disciplina se ocupa del diagnóstico y tratamiento de las enfermedades… (leer más)

El aumento del número de caballos que participan en exhibiciones y competiciones deportivas ha contribuido… (leer más)

El ozono es una variedad alotrópica de O2 que en condiciones normales se presenta en forma gaseosa. La forma de obtención… (leer más)

El área médica de la reproducción se aborda desde una doble vertiente con un único objetivo: el nacimiento de un potro sano… (leer más)

Al igual que sucede en medicina humana la prevención es un factor clave en el trabajo veterinario. Nuestro éxito radica en… (leer más)

El equipamiento médico de MC nos permite llevar a cabo cirugías de campo tales como castraciones, resección de tumores… (leer más)

Los problemas dentales pueden causar multitud de síntomas que comprometen el bienestar de tu animal e incluso dificultan su manejo… (leer más)

MC facilita toda la información y documentación necesaria para la correcta identificación de los caballos. Prestamos asesoramiento y… (leer más)

En MC Veterinaria Equina le ofrecemos la posibilidad de elaborar programas nutricionales individualizados… (leer más)
Clientes
YEGUADAS /GANADERÍAS
ESTUDIOS

Argenta (2024) // Argenta | Animal Health CRO/CDMO

Equi-Cord- Ymax (2017)
efficacy and safety study of allogeneic mesenchymal stem cells from umbilical cord for the treatment of clinical symptomatology associated with mild to moderate degenerative joint disease (osteoarthritis) in horses under field conditions
Ondax Scientific (2020)
Blog
Contacto
Contacto
Horario de atención
De Lunes a viernes de 09:00h. a 20:00h.
T.: (+34) 676 79 14 60
T.: (+34) 675 07 07 08
Mail: mdelacuesta.vet@gmail.com
_
Urgencias: 24 horas, fines de semana y festivos T.: (+34) 675 070 708





















